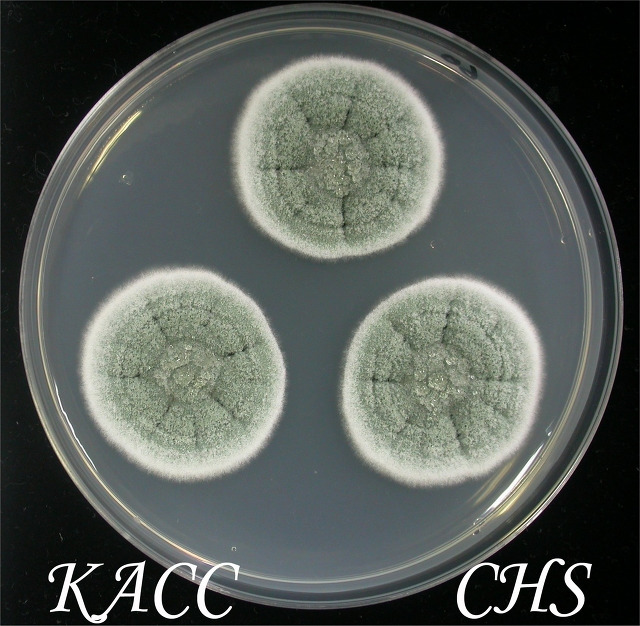
60_40399_CZA_O(2)-PS.jpg

페니실린 발견과 플레밍푸른곰팡이의 학명
곰팡이 이야기 19
알렉산더 플레밍의 페니실린 발견과 이의 치료약으로의 개발은 과학사에서 워낙 큰 획을 그은 사건이라서 많은 뒷 이야기들이 있습니다.
스토리를 간단히, 아주 간단히 소개하면 1929년에 플레밍은 자신이 배양하는 세균을 오염시킨 페니실리움 균주가 세균에 대한 생장억제력이 있다는 것을 발견하고는 '페니실륨 균주의 항생력에 대하여'라는 제목으로 영국실험병리학회지 (British Journal of Experimental Pathology) 에 발표합니다. Science, Nature 도 아니고 그저 평범한 저널로 알고 있습니다 (SCI 였겠지요? ^^).

의외로 쉬운 논문이니 한번 읽어 보세요. 전체 내용은 다음에 있습니다.
http://202.114.65.51/fzjx/wsw/newindex/wswfzjs/pdf/1929p185.pdf
이 논문은 그리 큰 주목을 받지 못하고, 그저 페니실리움이라는 곰팡이가 생산하는 페니실린이라는 물질이 세균에 대한 억제력이 있다 정도에 그쳤습니다. 플레밍은 이를 사람의 세균병 치료에 활용하지 못하였지요. 그저 쥐와 토끼에 주사하여 페니실린이 동물에게 큰 해를 끼치지 않는다 정도에 그쳤습니다. 해서 플레밍의 논문은 그냥 역사속에 묻힐 뻔 하였습니다.
하지만 이를 간과하지 않은 학자가 있었으니 그가 호주 출신으로 영국 옥스퍼드 대학에서 병리학 교수로 재직하던 하워드 플로리였습니다. 플로리는 39년에 페니실린 연구 건으로 록펠러 재단으로부터 25,000달러의 연구비를 수주하고 본격 연구에 들어가게 됩니다.
그는 페니실린을 어느정도 확보한 다음에 41년에는 실제 포도상구균(Staphylococcus aureus)의 감염으로 사경을 헤메는 경찰관에게 첫 투여를 하게 되지요. 확보한 페니실린의 물량 부족으로 결국 이 경찰관은 죽게 되지만 플로리는 페니실린을 세균병에 대한 치료제로 확신하게 됩니다.
페니실린으로 세균병 환자에 대한 몇번의 치료 시도와 실패를 겪으면서 플로리는 결국 페니실린의 정제와 대량확보가 관건이라고 결론을 내리고, 2차세계 대전으로 연구비도 따기 어렵고 불안정한 영국을 떠나 미국으로 건너가게 됩니다.
그는 당시의 페니실리움 대가 Thom을 찾았고, Thom은 그를 페오리아(Peoria)에 있는 미농무성 산하 북부시험장에 소개 시켜줍니다. (우리로 따지면 농촌진흥청 산하 영남시험장, 또는 호남시험장 쯤 된다고 보면 됩니다. 이 시험장은 우리와도 친숙하고 지금도 우리기관과 공동연구를 하고 있습니다)
여기에서 플로리는 북부시험장의 연구진들과 함께 페니실린 연구에 매진하였는데, 배지에 옥수수추출물을 첨가함으로서 10배 이상으로 페니실린 생산량을 늘렸습니다. 그리고 대박은 북부시험장의 계약직원이었던 메리라는 아가씨가 터뜨렸습니다. 이 아가씨는 우연히 페오리아 시장에서 곰팡이에 감염된 참외를 구입하게 되는데, 여기서 분리한 페니실리움 균이 엄청남 양의 페니실린을 생산하였습니다.
계약직원 메리가 분리한 곰팡이가 아래 사진의 바로 이 곰팡이입니다. 이 균주는 농업미생물은행 (KACC)에도 KACC 45966 번으로 보관되어 있습니다.
 메리가 발견하여 대박을 터뜨린 NRRL 1951 균주. NRRL의 후임 연구자인 W. Peterson 이 이 균주를 소개하고 있다(2008.9. 촬영)
메리가 발견하여 대박을 터뜨린 NRRL 1951 균주. NRRL의 후임 연구자인 W. Peterson 이 이 균주를 소개하고 있다(2008.9. 촬영)이러한 발견에다가 균주 육종까지 가미해서, 플로리는 미국에서 영국시절보다 250배 이상의 페니실린 생산 기술을 확보하게 되었고, 이는 결국 2차세계대전에서 세균감염으로 죽어가는 많은 젊은이의 생명을 구하게 되었습니다.
그런데, 좀 이상한 부분이 있지요? 우리는 페니실린 하면 플레밍인데, 실은 일은 다 플로리가 했쟎아요.
두가지 측면으로 해석할 수 있을 것 같습니다.
첫번째는 과학에서는, 특히 발명에서는 첫째가 중요하다는 부분을 이야기 할 수 있을 것 같고요,
두번째는 과학에도 정치 논리가 많이 반영됩니다.
영국왕립학회는 세균병을 잡는 페니실린이라는 과학사에서 획기적인 발견에 대하여, 여러가지 측면에서 의도적으로 플레밍을 띄웠습니다. 여러가지 측면은 스토리텔링(과학사를 드라마틱하게 꾸미고 싶었지요, 즉 플레밍을 신데렐라로 만들고 싶었습니다.), 그리고 페니실린의 발명과정에서 많은 부분을 미국에게 빼앗긴데 대한 자국 과학자의 의도적인 배려 등등, 자세한 이야기는 이 책에 있습니다.

(쉽게 쓰여진 책이더라고요, 한번 도전해 보세요. 실은 저도 이책은 아직 맛만 봤고 다른 소스를 통하여 얻은 지식을 아주 간단히 정리한 것이 위의 내용입니다. 제가 이 책을 다 읽게 되면 과학사에서 아주 흥미진진한 이 부분에 대하여 재미있게 글을 한번 올려 보겠습니다.)
딴 길로 많이 샛지만 이제 오늘의 주제로 들어갑니다.
며칠전에 플레밍이 발견한 페니실린을 생산하는 균주가 페니실리움 크리소게눔 (Penicillium chrysogenum)이 아니라 페니실리움 루벤스 (P. rubens)라는 논문이 발표되었습니다.
http://miranda.ingentaselect.co.uk/fstemp/393748efb55c2794d0edd3288990c654.pdf
내용을 말씀드려 볼께요.
먼저 플레밍이 발견한 균주 이름에 대한 역사입니다. 플레밍이 발견한 균주는 바로 이 균주입니다.
 플레밍이 처음 발견한 페니실린을 생산하는 곰팡이, KACC 44964
플레밍이 처음 발견한 페니실린을 생산하는 곰팡이, KACC 44964플레밍은 곰팡이 분류학자는 아니기 때문에 세균을 죽이는 이 균주를 발견한 후에, 같은 건물에 근무하는 곰팡이 전문가인 La Touche 박사에게 균주동정을 의뢰하게 됩니다 (우리도 좋은 생물농약 곰팡이를 발견하면 전문가한테 동정을 맏기쟎아요). La Touche 박사님은 Biourge라는 Penicillium 전문가의 책을 보고는 Penicillium rubrum 라고 이름 붙입니다.
이 후 이 균주는 미국의 페니실리움 전문가인 Thom에게 보내졌고, Thom은 플레밍이 균학적으로는 문외한이라고 생각했기 때문에 (실제로는 균학전문가인 La Touche 박사가 동정한 것을), 가볍게 여기면서 P. notatum으로 재동정하였습니다. 해서 1977년까지는 이 곰팡이 이름이 P. notatum 이었습니다.
그런데 네덜란드의 Samson 박사님이 P. notatum 을 연구해 보니 이것이 P. chrysogenum과 다를 바가 없더란 말입니다. 해서 그는 P. notatum을 선배격인 P. chrysogenum 으로 합칩니다. 해서 플레밍의 페니실린 생산곰팡이는 P. chrysogenum으로 이름을 바꾸게 되지요. 이 때 부터 플레밍의 페니실린 곰팡이, 그리고 메리가 발견하여 산업적으로 널리 사용하게 된 곰팡이 등 페니실린 생산 곰팡이 하면 P. chrysogenum 이 된것입니다. 지금까지요.
 플레밍 균주를 P. chrysogenum 으로 사용하게 한 Samson 박사님(좌)과 P. rubens로 바꿔야 된다고 주장하는 본 논문의 주저자 Jos Houbraken (우)
플레밍 균주를 P. chrysogenum 으로 사용하게 한 Samson 박사님(좌)과 P. rubens로 바꿔야 된다고 주장하는 본 논문의 주저자 Jos Houbraken (우) 이 과정에서 우여곡절도 있었지요.
89년에 Samson 박사님의 친구인 Frisvad 박사님이 이번에는 P. chrysogenum이 선배뻘인 P. griseoroseum과 한종이라고 주장하였습니다. Frisvad 박사님은 주로 분석화학적 방법을 통하여 이를 입증하였고 학계가 Frisvad의 주장에 동의하였습니다. 곰팡이 이름을 서로 합칠때는 후배가 선배를 따르게 되거든요. P. crysogenum은 1910년 출생이고 P. griseoroseum은 1901 년 출생이라 P. chrysogenum의 이름이 사라지게 될 운명에 처했습니다.
하지만 Firsvad 박사님은 이미 P. chrysogenum 이 너무 많이 알려진 이름이기 때문에 생소한 P. griseoroseum을 사용하기 보다는, 명명 상의 원리에는 맞지 않지만 일반인들의 혼란을 막기 위하여 P. chrysogenum을 그대로 살려두자고 합니다. 즉, P. griseorosem을 동의어로 처리하자 (즉 쉽게 이야기 해서 P. griseoroseu m을 없던 것으로 하자) 는 의견을 내었습니다. 이런 그의 주장이 곰팡이 명명위원회에서 받아들여져서 현재도 페니실린을 생산하는 페니실리움은 크리소게눔으로 불리고 있는 거지요. 이렇게 균학자들간의 합의에 의하여 살게 된 이름을 우리말로는 보존명, 라틴어로는 nom. cons.라고 합니다.
그런데, 이렇게 우여곡절을 겪으면서 살아난 P. chrysogenum 을 왜 이번에는 다시 페니실리움 루벤스로 바꾸는게 맞다고 하는 것일까요?
내용인즉슨 이렇습니다.
요즈음은 분자생물학 시대아닙니까. 저자인 Jos Houbraken (위 사진 참조)이 페니실린과 관련된 역사적으로 중요한 균주들을, 요즘 분류에 흔히 사용하는 tubuliin, calmodulin, RPB 유전자를 이용하여 유연관계도를 작성하였더니 다음 그림과 같은 결과가 나왔습니다 (더 깊히 이야기하면 다른 이유도 있긴 하지만 제일 중요한 근거가 이 계통도입니다).

그림의 맨위 두 그룹을 보세요. CBS 205.57 이 플레밍 균주이고, CBS 307.48 이 NRRL 계약직 아가씨 메리가 분리하여 대박낸 균주인데, 이들은 P. rubens의 표준균주인 NRRL 792와 같은 묶음에 있어요. 대신에 P. chrysogenum 표준균주인 CBS 306.48 와는 다른 그룹에 있어요. 그런데 P. rubens와 P. chrysogenum 묶음은 서로 명확히 다르고 거리가 멀기 때문에 다른 종이라는 것입니다. 결국 플레밍균주 CBS 205.57은 더 이상 P. chrysogenum이 아니라 P. rubens로 독립해야 한다는 것입니다.
균학자의 입장에서 타당한 주장입니다. 이 논문에는 이런 내용도 있습니다.
플레밍과 같은 건물에 근무하던 La Touche (플레밍 곰팡이를 처음 이름붙인 사람)가 곰팡이와 천식과의 관계를 연구하였는데, 그는 실내공기중 곰팡이, 특히 거미줄에 묻어 있는 곰팡이를 연구하였는데, 그가 모아 놓은 곰팡이 중에 하나가 날아가서 플레밍의 세균 배양 플레이트를 오염시켰을 것이다라는 것입니다.
그건 그렇고, 결국은 일반인들 그리고, 학생들은 다시 혼란스럽게 되었습니다.
플레밍이 발견한 페니실린을 만드는 곰팡이는 페니실리움 크리소게눔이다라고 어려운 발음이 나는 것을 겨우 외워났는데, 이것이 크리소게눔이 아니고 루벤스라니 또 어떻게 외운다는 말입니까? 게다가 페니실리움 크리소게눔은 원래는 페니실리움 그리세오로지움이 되어야 맞는데, 크리소게눔의 유명세 때문에 억지로 살아남았는데, 이번에는 루벤스로 바꾸자니......,
곰팡이 분류학자의 입장도 또한 난처합니다.
곰팡이 명명의 원칙을 따르자면 루벤스가 맞는데, 이미 크리소게눔으로 일반인들에게 다 알려져 있으니, 이것을 고치자니 어렵고 그냥 두자니 원칙에 맞지 않고, 말 그대로 딜레마에 빠져 있습니다.
여러분 의견은 어떻습니까?
플레밍의 균주, 그리고 메리가 대박낸 균주를 크리소게눔으로 그대로 두는게 나을까요, 아니면 루벤스로 고치는 것이 나을까요? 답을 한번 해 보세요.
정답은?
10년 쯤 후에 가면 나오겠지요. 어떤 이름이 많이 쓰이는지.
아니 이건 무슨 운명의 장난....,
열심히 글을 쓰고 점심을 끓여 먹으려고 냉장고에서 쌀떡을 꺼냈는데, 이게 이번 네덜란드 방문에서의 나의 마지막 식량인데, 페니실리움 곰팡이가 먼저 제 식량에 입을 데어 버렸네요. 내가 페니실리움, 지들 이야기 하는 지는 어떻게 알고, 이렇게 방문을 했을까요?
<2011. 6. 12. 네덜란드 CBS Fungal Biodiversity Center 에서>